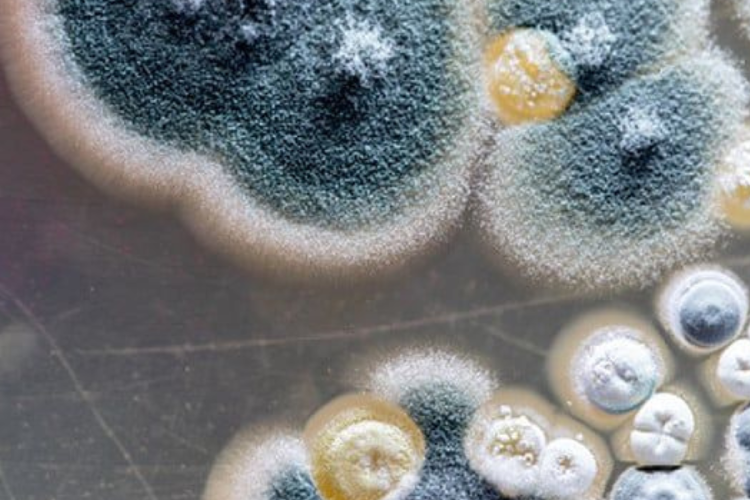
hongo El Candida auris se ha reportado en más de 40 países. En algunos casos, ha causado brotes intrahospitalarios difíciles de controlar. (Imagen: Pinterest)

Crece la alarma por el hongo más agresivo del mundo y los científicos advierten que se expande con rapidez, resiste a los tratamientos y ya encendió alertas en varios países. ¿Por qué este patógeno pone en jaque al sistema de salud?
¿De qué hongo estamos hablando?
Se trata de Candida auris, un hongo emergente considerado uno de los más peligrosos y resistentes del mundo. Fue identificado por primera vez en 2009, pero en los últimos años su propagación se volvió imparable. Su capacidad para sobrevivir en superficies, resistir medicamentos antimicóticos y causar infecciones graves lo convierte en una amenaza global.
También te puede interesar: ¿Riesgo biológico?: Un virus de hace 48.500 años fue revivido
¿Por qué genera tanta preocupación?
- Es altamente resistente a los tratamientos convencionales.
- Tiene una alta tasa de mortalidad en pacientes inmunodeprimidos.
- Se propaga con facilidad en hospitales y centros de salud.
- Puede vivir en superficies durante semanas, lo que dificulta su erradicación.
- No siempre se detecta fácilmente: los síntomas pueden confundirse con los de otras enfermedades.
Brotes en hospitales: el nuevo COVID silencioso
El Candida auris se reportó en más de 40 países. En algunos casos, ha causado brotes intrahospitalarios difíciles de controlar. Su comportamiento ha llevado a varios expertos a compararlo con un “COVID silencioso”, debido a su forma de propagación y resistencia.
Algunos medios ya hablan de una pandemia fúngica en cámara lenta, que crece mientras la opinión pública mira para otro lado.
¿Qué países están más afectados?
Estados Unidos, India, Japón, España, Reino Unido y varios países de América Latina ya han reportado casos preocupantes. En hospitales argentinos también se han detectado contagios, aunque sin una difusión mediática masiva.
¿Hay forma de prevenirlo?
Actualmente no hay una vacuna ni tratamiento 100% efectivo. Sin embargo, las medidas de control incluyen:
Higiene extrema en entornos clínicos
Diagnóstico temprano
Aislamiento de pacientes infectados
Supervisión de brotes en tiempo real
¿Por qué nadie habla de esto?
El Candida auris no causa estragos masivos en la población general, pero afecta gravemente a personas inmunocomprometidas, como pacientes oncológicos, trasplantados o con enfermedades crónicas. Su “bajo perfil mediático” contrasta con su impacto real en sistemas de salud.
Expertos advierten que la falta de visibilidad y la subestimación de los hongos resistentes podría costar caro en el futuro cercano.
Global
